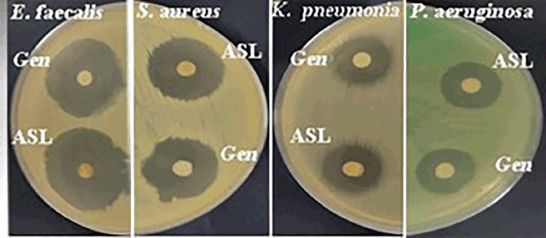

INTRODUCTION
For centuries, medicinal plants have played a crucial role in managing various diseases, with many cultures incorporating them into their traditional medicine practices. Adenium socotranum (Vierh.), an endemic plant of Socotra Island, is commonly known as “Trimo” or “Asfed”. This succulent plant belongs to the Apocynaceae family and is considered the largest species within the Adenium genus. Mature plants are conical in shape, characterized by a thick upright trunk capable of storing large quantities of water, and several short branches merging from the top of the plant. The plant can reach up to 3 m in diameter and 5 m in height. The leaves of A. socotranum are obovate, dark green, and alternately arranged, forming clusters at the tips of the stem branches, which emerge in winter and shed in summer. The plant produces pink flowers and cylindrical follicular fruits [1,2]. Traditionally, the species has been used to treat inflamed and ulcerated skin in both humans and animals. Its application involves crushing the plant leaves and applying the expressed directly to the skin [1].
Effective wound care remains a major clinical concern, especially when complicated by underlying conditions [3]. While a typical wound healing process takes about 7–10 days, chronic wounds can persist for months or even years due to complicating factors such as diabetes, infections, medications, and aging [4]. These non-healing wounds not only incur high financial costs, but also cause severe pain, infection, and potential loss of function [5]. Despite extensive research into wound care, effectively treating these persistent wounds remains a formidable clinical challenge [6].
Among the major contributors to wound chronicity is the presence of microbial infections. Bacterial infections are a major factor in delayed wound healing, particularly in individuals with diabetes. The overuse of antibiotics has led to significant issues and adverse effects like allergies and immunosuppression [7]. Therefore, there is a pressing need to explore alternative sources of antibiotics, including plants.
In addition to infection, another key factor that impedes wound healing is oxidative stress. Oxidative stress, particularly from reactive oxygen species (ROS), can hinder wound healing [8]. Elevated levels of free radicals accompany numerous diseases, such as malignancies, autoimmune diseases, ageing, cardiovascular events, and neurodegenerative issues, to name a few [9]. Consuming antioxidants has been shown to reduce the risk of acquiring these diseases [10]. Antioxidants are crucial in restoring injured skin to normalcy as the regulation of ROS and other free radicals is vital during the wound healing processes. By normalizing ROS levels, wound regeneration can be accelerated [11].
Although A. socotranum has been widely used in traditional medicine, there is a lack of published research regarding its phytochemical composition and associated biological activities. This study aims to fill that gap by analyzing the chemical constituents of A. socotranum and evaluating its antioxidant, antimicrobial, and wound healing activities. To further elucidate the potential mechanisms of action, molecular docking simulations were conducted to explore the interactions of the identified compounds with tumor necrosis factor-alpha (TNF-α) and TGF-βR1 (TGF-βR1), aiming to identify the key molecules responsible for the observed wound healing effects.
MATERIAL AND METHODS
Chemicals, standards, and reagents
Methanol (96%), ethanol (96%), diethyl ether, Tween 20, formalin, and formic acid, were procured from Scharlau chemicals (France). Standard hydroxyproline was obtained from BDHL Laboratory (England). 2,2-diphenyl-1-picrylhydrazyl (DPPH; Sigma, Germany) was used as a source of free radicals for the antioxidant assay, with vitamin C (Sigma, USA) used as a positive control. For total phenolic content (TPC), Folin–Ciocalteu reagent and gallic acid (GA) were acquired (Labo Chemie, India). For Hydroxyproline content determination, H2SO4 (Highmedia, India), NaOH (Fluka Chemie, Switzerland), CuSO4 (BDHL Laboratory, England), H2O2 (Carl Roth, Germany), HCL (Highmedia, India), and P-Dimethylaminobenzaldehyde (Highmedia, India), were used. For wound healing studies, ketoprofen (Ketofan®, Egypt) and Solcoseryl® Jelly 10% (Meda Pharmaceuticals, Switzerland) were used. For antibacterial testing, gentamicin discs (10 µg) (Highmedia, India) were used as a positive control. All chemicals used in the experimental procedures were of analytical grade purity.
Plant material and extract preparation
In September 2019, leaves of A. socotranum (ASL) were collected from Socotra Island and identified at the office of the Environment Protection Authority, Socotra branch, Yemen. The leaves were thoroughly cleaned, dried, and ground into a powder. A total of 404.8 g of the powdered leaves was macerated in 96% methanol at room temperature for 1 week, with this process repeated 4 times. The resulting extract was filtered, and the filtrate was dried using a rotary evaporator (Buchi, Switzerland) at 45°C–50°C. The yield of extract, based on the dry weight of the plant powder, was calculated to be 83.3 g (20.6%).
Experimental animals
A total of 25 mature male albino rats, weighing between 200 and 250 g, were obtained from the animal house at the Faculty of Science, Sana’a University, Yemen. The rats were housed in polypropylene cages and kept under the following controlled conditions: a 12-hour light/dark cycle, temperature maintained at 25°C ± 3°C, and humidity between 35% and 60%. Strict hygienic conditions were maintained, and the animals had access to food and water ad libitum. Prior to the experiments, the rats underwent a one-week acclimatization period to adapt to the laboratory environment.
Phytochemical screening
Preliminary phytochemical analyses were conducted using established protocols tailored for the detection of various phytochemical classes. These included alkaloids, carbohydrates, tannins, saponins, flavonoids, alkaloids, quinones, terpenoids, triterpenoids, glycosides, phenols, coumarins, proteins, cardiac glycosides, steroids, and phytosterols [12–14].
Determination of TPC
The TPC of ASL was determined using the Folin–Ciocalteu assay following protocols described by Moharram et al. and Waterhouse [15,16]. Briefly, 500 µl of sample (1 mg/ml) was mixed with 0.5 ml of Folin-Ciocalteu’s phenol reagent. After 2.5 minutes, 10 ml of a 7% Na2CO3 solution and 13 ml of distilled water were added and thoroughly mixed. GA was used as a standard, and various concentrations (10, 20, 30, 40, 50, 60, 80, and 100 μg/ml) of it were prepared similarly to the sample. A blank was also prepared following the same procedure as the sample. All mixtures were kept in the dark for 90 minutes at 23°C to allow for the reaction and blue color formation. Absorbance was then measured at 725 nm. The TPC was calculated from the standard calibration curve using the linear equation y = 0.03x − 0.157, where y is the absorbance and x is the concentration of GA equivalent (GAE) in mg/ml. The coefficient of determination (R2) for the calibration curve was 0.9926. The TPC of ASL was expressed as mg of GAEs per gram of extract (GAE mg/g).
Gas chromatography–mass spectrometry analysis
The chemical analysis of ASL extract was conducted using a Trace GC1310-ISQ mass spectrometer (Thermo Scientific, Austin, TX ) equipped with a direct capillary column TG–5MS (30 m × 0.25 mm × 0.25 µm film thickness). Initially, the column was maintained at 35°C and subsequently ramped up at a rate of 3°C per min until it reached 200°C, where it was held steady for 3 minutes. Following this, the temperature was further increased to the final set point of 280°C at a rate of 3 °C/min and maintained for 10 minutes. The injector and MS transfer line were maintained at temperatures of 250°C and 260°C, respectively; Helium served as the carrier gas at a constant flow rate of 1 ml/min. A solvent delay of 3 minutes was implemented, and an automated injection of diluted samples (1 µl) was conducted using AS1300 Autosampler coupled with GC operating in split mode. Electron ionization mass spectra were recorded using 70 eV ionization voltages across the m/z range of 40–1,000 in full scan mode. The ion source temperature was maintained at 200°C. The plant phytochemical constituents were identified by comparing their mass spectra with entries from the WileyRegistry8e and Replib mass spectral database.
Antioxidant activity
The antioxidant activity of ASL extract was assessed using the DPPH-free radical scavenging assay as described in our previous research [17]. In brief, the stock solution of the ASL extract (10 mg/ml in methanol) was serially diluted to obtain 7 concentrations: 2,000, 1,000, 500, 250, 125, 62.5, and 31.25 μg/ml. For the assay, 100 μl of each dilution was dispensed into the wells of a microtiter plate. Subsequently, 100 μl of DPPH solution (0.1 mmol in methanol) was added to each well, and the plate was shaken on a microtiter shaker for 1 minute. The mixture was then incubated at room temperature for 30 minutes.
The reduction of the DPPH free radical was measured by reading the absorbance at 492 nm using a microplate spectrophotometer (LINEAR GEA, Spain). Methanol was used as the negative control, while vitamin C, prepared in concentrations ranging from 3.125 to 100 μg/ml, served as the positive control. Blank solutions containing the extracts without DPPH were also included to account for background absorbance. The percentage inhibition of DPPH radicals was calculated using the following equation ( each experiment was carried out in triplicate):
% inhibition = [Abc − (Ab1 − Ab0)]/Abc × 100
Abc = absorbance of the control, Ab1 = absorbance of the extract with DPPH, Ab0 = absorbance of the blank (sample blank).
Antibacterial activity
The bacterial strains used in this study included the Gram-positive bacteria Enterococcus faecalis (ATCC 10541) and Staphylococcus aureus (ATCC 6538), and the Gram-negative bacteria Klebsiella pneumoniae (ATCC 13883) and Pseudomonas aeruginosa (ATCC 90274). All bacteria were sourced from the Regional Center for Mycology and Biotechnology, Al-Azhar University, Cairo, Egypt. The antibacterial activity of ASL against these bacteria was evaluated using disc-diffusion and microdilution methods, following protocols as described in previous studies [18,19].
Initially, bacterial inocula were prepared by adjusting the OD600 value to achieve an equivalent of 108 CFU/ml, determined from a calibration curve specific to each bacterial species.
The disc-diffusion method was conducted following the guidelines of the National Committee for Clinical Laboratory Standards [19]. In brief, 100 μl of microbial suspension (108 CFU/ml) was evenly spread onto agar plates. Filter paper discs, approximately 6 mm in diameter, containing the extract at a concentration of 1 mg/ml, were then placed on the agar surface. Petri dishes were subsequently incubated for 24 hour at 37°C. Following incubation, the growth of microorganism’s growth was assessed, and the diameters of the zones of inhibition were recorded in millimeters. The size of the clear zone observed is directly proportional to the inhibitory effect of the extract under investigation. Gentamycin, an antibiotic, served as a positive control in these experiments.
The antibacterial efficacy of ASL extract was assessed using the microdilution method to establish the minimum inhibitory concentration (MIC). The extract was solubilized in Mueller Hinton broth (MHB) to create a stock solution of 1,000 µg/ml. Next, 100 µl of this stock solution was added to each well in column 1 of a microtiter plate, while columns 2–10 were filled with 50 µl of MHB. Column 11 received 100 µl of the diluted standardized inoculum, and column 12 was filled with 100 µl of MHB to act as a sterility control. A multichannel pipette was used to transfer and mix 50 µl of the extract from column 1 to 2, and this process was repeated from column 2 to 3, continuing through to column 10. This created a series of double serial dilutions, resulting in tested extract concentrations ranging from 1,000 to 2.0 µg/ml in each well. The standardized bacterial suspension was then diluted by 1:100 with MHB broth. Subsequently, 50 µl of the diluted OD600 bacterial suspension was added to each well containing the extract, as well as to the control wells. This process resulted in an approximate bacterial concentration of 5 × 105 CFU/ml in each well, with the final extract concentrations extract ranging from 500 to 1.0 µg/ml. Following a 24 hours incubation period at a temperature of 37°C, the plates were incubated for an additional 2–4 hours to monitor any changes in color after the addition of 30 µl of resazurin solution (0.015%). Wells that retained the blue color of the resazurin solution were recorded as having concentrations above the MIC value [18,19]. All MIC studies were conducted in triplicates.
In vivo wound healing activity (excision wound model)
In vivo woud healing procedure followed a protocol described previously by us [20]. In brief, rats were anesthetized via ether. Before a subcutaneous injection of 5 mg/kg ketoprofen, an analgesic was administered prior to surgery and repeated every 24 hours for 2 days. The dorsal area of each rat was shaved with an electric shaver and cleaned using a cotton swab soaked in 70% alcohol. An 8 mm uniform wound was created at the nape of the dorsal neck of all rats using a circular biopsy bunch [21]. The wounds extended into the lower subcutaneous tissue. Rats were randomly allocated into five groups, each containing five rats. Group 1 served as the untreated control. Group 2 received topical applications of 0.2 ml distilled water (vehicle) twice daily at the wound site for 12 days. Groups 3 were treated with 0.2 ml of 10% Solcoseryl jelly, serving as the positive control. Groups 4 and 5 received topical treatments with 0.2 ml of ASL extract at concentrations of 10 and 20 mg/ml, respectively. Each rat was individually housed in cages, and wound area contraction was manually measured in square millimeters. The progression of wound closure was monitored by recording wound area on days 0, 3, 6, 9, and 12 post-injury using transparent paper and a permanent marker, following methods described elsewhere [22]. Wound areas were quantified using graph paper.
The percentage of wound closure was calculated using the following equation:
% wound closure = 1 − (wound area at day 0/wound area on the corresponding day) × 100
Hydroxyproline content determination
Hydroxyproline content was assessed to quantify collagen synthesis in both normal and healed wound tissues. The estimation was done following the methods described in previous studies [23,24]. Briefly, tissues weighing approximately 0.15 g were excised and dried in a hot air oven at 60°C–70°C until a constant weight (0.002–0.03 g) was achieved. The dried tissues were hydrolyzed in sealed test tubes using 6N HCL solution (5 ml) at 100°C for 24 hours. Following hydrolysis, the samples were neutralized to pH 7 with 6N NaOH solution and centrifuged at 4,000 rpm for 15 minutes. From each hydrolysate, 1 ml of the supernatant was transferred to separate test tubes. Another test tube marked ‘B’ contained 1 ml of distilled water and served as a blank. To each test tube, 1 ml of 0.01M CuSO4 solution, 2.5N NaOH, and 6% H2O2 solution were added and vortexed for 5 minutes, followed by incubation at 80°C with shaking for 5 minutes. After cooling, 4 ml of 3N H2SO4 solution was also added with shaking. After adding 2 ml of p-dimethylaminobenzaldehyde solution, prepared with 5% propanal, to each tube, they were then incubated for 16 minutes at 70°C. Subsequently, all test tubes were cooled, and their absorbance was measured at a wavelength of 572 nm.
The hydroxyproline content was assessed by preparing a standard curve using dilutions of a 1 mg/ml stock solution of hydroxyproline, yielding final concentrations ranging from 2 to 200 μg/ml (2, 10, 25, 50, 100, and 200 μg/ml). Hydroxyproline content in each sample solution was determined using the equation derived from the curve (y = 0.0017x + 0.0557). Results were expressed as μg hydroxyproline per mg of skin tissue.
Histopathological studies
Biopsies of normal (at day 0) and healed skin tissues collected at day 12 post-surgery from each rat were fixed in 10% neutral buffered formalin. These underwent dehydration in graded ethanol, clearing in xylene, embedding in paraffin, and blocking out. After that, 5 μm-thick sections of the tissues were mounted on glass slides and rehydrated in distilled water and stained with hematoxylin and eosin according to Bancroft et al. [25]. Evaluation included the regenerated tissues, formation of granulation tissue formation, and deposition and organization of collagen.
Molecular docking
Co-crystallized structures of two key proteins related to wound-healing, TNFα and TGF-βR1, were selected for molecular docking studies. The crystal structures of these proteins were retrieved from the Protein Data Bank (http://www.rcsb.org/pdb), accessed on 1 April 2025 with PDB IDs: 2AZ5 (resolution 2.10 Å) for TNFα and 6B8Y (resolution 1.65 Å) for TGF-βR1. Molecular docking simulations were performed using the molecular operating environment (MOE)-Dock module within MOE 2019 software [26]. The protein structures were prepared by removing water molecules and non-essential ligands with MOE’s quick preparation tool. Active sites were determined using the Site Finder tool, which matched the sites with those of known co-crystallized inhibitors. Dummy atoms were placed at active sites to define the docking site. The ligand library included phytochemical compounds identified via gas chromatography-mass spectroscopy (GC-MS), which were retrieved in both 2D and 3D formats from PubChem and prepared using Chem Draw Professional 15, along with standard inhibitors for TNFα and TGF-βR1. These ligands were docked into the defined active sites of the prepared proteins. The docking procedure involved setting the active site using the Site Finder tool, selecting ligand atoms for docking, and using the alpha triangle method for ligand placement. London dG was chosen as the scoring function, with default settings. Ligands were saved in MDB format and loaded into the program for automatic docking calculations. The triangular matcher was used for ligand placement, London dG for scoring, and rigid receptor refinement was applied. For each ligand, 100 poses were generated, and the best-scoring pose was chosen. The top-ranked protein-ligand complexes were analyzed for their fit within the binding pockets, and the most favorable conformations were selected for further analysis [27].
Statistical analysis
The data were analyzed using the Statistically Package for Social Sciences version 11.5. Results were expressed as means ± SD. Graph Pad Prism version 5.0 was utilized to determine IC50 values. Paired t-test and ANOVA were used to test the significance of the differences between every two groups. With a significance level set at 0.05.
RESULTS
Phytochemical screening
The phytochemical test of ASL extract revealed several bioactive compounds. The major constituents included phenols, flavonoids, tannins, carbohydrates, phytosterols, triterpenes, diterpenes, saponins, and cardiac glycosides.
TPC and antioxidant activity
The TPC of the ASL extract was determined using a calibration curve based on various concentrations of GA. The extract exhibited a high phenolic content of 14.0 mg GAE/g (Table 1). Additionally, the ASL extract demonstrated significant antioxidant capacity, exhibiting an IC50 value of 32.4 µg/ml. For comparison, ascorbic acid, used as a positive control, showed a significant antioxidant effect but with a lower IC50 value of 13.5 µg/ml (Table 1).
Table 1. TPC and antioxidant effect of A. socotranum leaf extract.
| TPC (mg GAE/g) | IC50 antioxidant activity (μg/ml) | |
|---|---|---|
| ASL extract | 14.0 ± 0.0 | 32.4 |
| Ascorbic acid | - | 13.5 |
‘-’ = not determined.
GC-MS analysis
The GC-MS spectra of ASL extract (Fig. 1) revealed the presence of 31 components. The identified compounds are listed in Table 2, including only those with a library direct matching value (SI) higher than 700. Table 2 also provides details on retention time (RT), percentage of area peak, molecular weight (MW), and chemical formula. The major compounds constituting 2% or more included methyl palmitate (35.22%), methyl stearate (22.21%), α-tocospiro A (2.26%), β-sitosterol (4.55%), and α-amyrin (7.35%).
Table 2. Percentage composition of ASL extract detected by GC-MS.
| No. | Components | RT | AP (%) | SI | MW | Formula |
|---|---|---|---|---|---|---|
| 1 | Methyl tetradecanoate | 41.40 | 1.11 | 751 | 242 | C15H30O2 |
| 2 | Methyl palmitate | 48.24 | 35.22 | 929 | 270 | C17H34O2 |
| 3 | Methyl 14-methylhexadecanoate | 51.35 | 0.66 | 724 | 284 | C18H36O2 |
| 4 | Methyl 10-octadecenoate | 53.47 | 1.56 | 809 | 296 | C19H36O2 |
| 5 | Methyl stearate | 54.57 | 22.21 | 931 | 298 | C19H38O2 |
| 6 | Arachidic acid methyl ester | 61.57 | 1.67 | 709 | 326 | C21H42O2 |
| 7 | 1,2-benzenedicarboxylic acid | 67.21 | 0.73 | 784 | 390 | C24H38O4 |
| 8 | Behenic acid methyl ester | 67.55 | 0.72 | 714 | 354 | C23H46O2 |
| 9 | Methyl lignocerate | 72.77 | 0.98 | 743 | 382 | C25H50O2 |
| 10 | α-tocospiro B | 75.24 | 1.85 | 717 | 462 | C29H50O4 |
| 11 | α-tocospiro A | 75.78 | 2.26 | 742 | 462 | C29H50O4 |
| 12 | Methyl hexacosanoate | 77.49 | 0.92 | 753 | 410 | C27H54O2 |
| 13 | Stigmasterin | 83.62 | 1.82 | 703 | 412 | C29H48O |
| 14 | β-sitosterol | 85.02 | 4.55 | 799 | 414 | C29H50O |
| 15 | Betulinaldehyde | 85.77 | 1.67 | 726 | 440 | C30H48O2 |
| 16 | α-amyrin | 86.55 | 7.35 | 819 | 426 | C30H50O |
AP = area peak; MW = molecular weight; RT = retention time; SI = direct match value.
 | Figure 1. GC-MS spectrum of ASL extract. [Click here to view] |
Antibacterial activity
Using disc-diffusion analysis, the ASL extract exhibited bactericidal effects nearly equivalent to those of gentamicin, a standard antibiotic, against all tested bacterial species (Fig. 2, Table 3). The extract demonstrated the highest activity against E. faecalis and S. aureus, with inhibition zones of 31.7 and 22.7 mm, respectively. Using the broth microdilution method, the ASL extract showed the greatest activity against E. faecalis, with an MIC value of 13.7 µg/ml, which was comparable to that of gentamicin (6.5 µg/ml). Conversely, the extract exhibited the lowest antibacterial activity against P. aeruginosa with an MIC value of 88.6 µg/ml (Table 3). The ASL extract also showed a strong antibacterial effect on S. aureus and K. pneumoniae, exhibiting MIC values of 39.1 µg/ml. However, this activity was not as potent as that of gentamicin, which had MIC values of 19.5 and 13.7 µg/ml, respectively.
| Figure 2. Inhibition zones for leaves of A. socotranum (ASL) and gentamicin (Gen) on E. faecalis, S. aureus, K. pneumoniae, and P. aeruginosa. [Click here to view] |
Table 3. Inhibition zone and MIC for A. socotranum leaf extract.
| Bacteria species | Inhibition Zone (mm) | MIC (µg/ml) | |||
|---|---|---|---|---|---|
| A. socotranum | Gentamicin | A. socotranum | Gentamicin | ||
| E. faecalis | 31.7 ± 0.6 | 28.3 ± 0.6 | 13.7 ± 2.8 | 6.5 ± 2.3 | |
| S. aureus | 22.7 ± 0.6 | 21.7 ± 0.6 | 39.1 ± 11.0 | 19.5 ± 5.5 | |
| K. pneumoniae | 17.7 ± 1.5 | 17.7 ± 0.6 | 39.1 ± 11.0 | 13.7 ± 2.8 | |
| P. aeruginosa | 16.7 ± 0.6 | 16.3 ± 0.6 | 88.6 ± 7.4 | 27.3 ± 5.6 | |
Data represent mean values ± SD, n = 3.
Wound-healing activity
Closure area of wounds (in mm2) for the rat groups tested was recorded on days 0, 3, 6, 9, and 12 after inducing injury (Fig. 3, Table 4). The ASL extract showed dose- and time-dependent wound healing activity. At high concentration (20 mg/ml), the extract showed significant wound healing (p < 0.05–0.001) from day 3 until day 12 after injury induction in animals’ dorsal necks, compared to the untreated and vehicle groups. However, at a lower concentration (10 mg/ml), the extract did not exhibit significant wound healing activity (p > 0.05) on day 3 compared to the untreated and vehicle groups. Furthermore, on day 3 post-treatment, the 20 mg/ml extract showed a significant reduction (p < 0.01) in wound area with a percentage inhibition of 61.1% compared to the 10 mg/ml extract, which had a 45.1% inhibition. Interestingly, on days 3 and 12 post-treatment, the 20 mg/ml ASL extract exhibited a significant reduction in wound area (29.2 and 0.4 mm2, respectively) compared to Solcoseryl jelly, a standard wound-healing drug (37.8 and 1.2 mm2, respectively), with p < 0.01 and 0.05, respectively. However, there was no significant difference in wound healing (p > 0.05) between the 10 mg/ml extract and Solcoseryl jelly on days 3, 6, and 12 post-treatment.
Table 4. Effect of ASL on wound closure area in experimental rats.
| Wound area in mm2 (% wound healing) | |||||
|---|---|---|---|---|---|
| Groups | D0 | D3 | D6 | D9 | D12 |
| Untreated | 75.0 ± 1.4 | 49.2 ± 2.0 (34.4 ± 2.6) | 36.3 ± 2.6 (51.2 ± 3.5) | 18.6 ± 1.0 (75.2 ± 1.3) | 5.2 ± 0.5 (93.1 ± 0.6) |
| Vehicle | 75.0 ± 1.4 | 39.0 ± 1.5a2 (48 ± 2.1) | 25.6 ± 2.1a3 (66.0 ± 2.8) | 14.4 ± 0.9a2 (80.8 ± 1.2) | 2.8 ± 0.4a2 (96.3 ± 0.5) |
| Solcoseryl jelly (10%) | 75.0 ± 1.4 | 37.8 ± 1.7a2 (49.6 ± 2.3) | 17.4 ± 1.3a3 (76.8 ± 1.8) | 6.8 ± 0.7a3 (90.9 ± 0.9) | 1.2 ± 0.4a3 (98.4 ± 0.5) |
| ASL (10 mg/ml) | 75.0 ± 1.4 | 41.2 ± 2.5 (45.1 ± 3.4) | 17.4 ± 1.1a2b1 (76.8 ± 1.5) | 9.0 ± 0.7a2b2c1 (88.0 ± 0.9) | 1.6 ± 0.5a2 (97.9 ± 0.6) |
| ASL (20 mg/ml) | 75.0 ± 1.4 | 29.2 ± 1.9a3b2c1d2 (61.1 ± 2.5) | 15.0 ± 1.0a2b1 (80.0 ± 1.4) | 7.6 ± 0.7a3b3 (89.9 ± 0.9) | 0.4 ± 0.2a3b3c1 (99.5 ± 0.3) |
Data represent mean values ± SED, n = 5. ASL = leaves of A. socotranum, a = significance compared to the untreated groups; b = significance compared to the vehicle group; c = significance compared to the Solcoseryl jelly group, d = compared to other extract groups. 1p < 0.05, 2p < 0.01, 3p < 0.001 was considered significant.
 | Figure 3. Macroscopic appearance of wounds from untreated, vehicle, Solcoseryl jelly, and ASL extract (10 and 20 mg/ml) at days 0, 3, 6, 9, and 12. [Click here to view] |
Hydroxyproline content
On day 12, both the 10 and 20 mg/ml ASL extract groups showed a significant difference in hydroxyproline content compared to the normal and vehicle groups (Fig. 4). The extract demonstrated dose-dependent activity, with the hydroxyproline content of the 20 mg/ml extract significantly higher (81.2 μg/ml) than that of 10 mg/ml extract (71.3 μg/ml; p < 0.01). Interestingly, both the 10 and 20 mg/ml extracts exhibited a significant increase in hydroxyproline content compared to the Solcoseryl jelly group (61.0 μg/ml), a standard wound-healing drug, with p-values of < 0.01.
 | Figure 4. Hydroxyproline contents for wounds analyzed for significance using paired t-tests with the following criteria: a = significance compared to the normal tissues group; b = significance compared to the untreated group; c = significance compared to the vehicle group, d = significance compared to Solcoseryl jelly group; e = significance among ASL extract groups. The data represent mean values ± SD (vertical bars), n = 5. A significance level of 1p < 0.05, 2p < 0.01, and 3p < 0.001 was considered significant. [Click here to view] |
Histopathological examination
Histopathological analysis of scars formed 12 days after initial wound induction is illustrated in Figures 5–7. Both the vehicle-treated and untreated groups exhibited similar histological features: minimal epithelization (Fig. 5), sparse collagen fibers (Fig. 6), and few blood vessels (Fig. 7). Notably, the untreated group showed higher inflammation compared to the vehicle-treated group (Fig. 6). In contrast, wounds treated with either the ASL extract or the Solcoseryl jelly showed markedly reduced scar width in comparison to those in the vehicle and untreated groups (Fig. 5). Moreover, wounds treated using the ASL extract displayed complete coverage by newly formed skin layer. That was associated with, with development of hair as well as sebaceous glands (Fig. 5). In addition, the extracellular matrix was notably contained abundance of collagen (Fig. 6). Furthermore, ASL treatment promoted increased angiogenesis, denser collagen fiber formation, with fewer numbers of white blood cells within the recently formed granulation tissue (Figs. 6 and 7).
 | Figure 5. Histological evaluations of skin tissues from experimental groups on day 12 post-wounding, stained with hematoxylin and eosin (H&E) (100× and 400× magnification). N (normal skin): Displays intact epidermis (EP). G1 (untreated control): shows incomplete healing with less epithelialization (arrow). G2 (vehicle-treated): Demonstrates partial re-epithelialization (RE). G3 (solcoseryl-treated): Exhibits complete re-epithelialization (RE). G4 (ASL extract, 10 mg/ml): Shows full re-epithelialization G5 (ASL extract, 20 mg/ml): Reveals thick, complete re-epithelialization (RE) with abundant hair follicle and sebaceous gland formation (arrows). [Click here to view] |
 | Figure 6. Histological evaluations of skin tissues from experimental groups on day 12 post-wounding, stained with hematoxylin and eosin (H&E) (100× and 400× magnification). N (normal skin): densely packed collagen fibers. G1 (untreated control): Shows reduction in collagen deposition and marked inflammatory infiltration (arrow). G2 (vehicle-treated): Demonstrates minimal collagen content with mild inflammatory cells (arrows). G3 (solcoseryl-treated): Exhibits moderate collagen density. G4 (ASL extract, 10 mg/ml): Shows dense collagen fibers. G5 (ASL extract, 20 mg/ml): Reveals dense collagen deposition. [Click here to view] |
 | Figure 7. Histological evaluations of skin tissues from experimental groups on day 12 post-wounding, stained with hematoxylin and eosin (H&E) (100× and 400× magnification). N (normal skin): Displays numerous blood vessels. G1 (untreated control): Shows sparse blood vessel formation (arrow). G2 (vehicle-treated): Demonstrates limited blood vessels (arrows). G3 (solcoseryl-treated): Exhibits sparse blood vessel presence. G4 (ASL extract, 10 mg/ml): Shows a rich network of blood vessels (arrows). G5 (ASL extract, 20 mg/ml): Reveals extensive neovascularization (arrows). [Click here to view] |
Molecular docking study
The ASL extract exhibited significant biological activity and promising wound-healing properties. To further understand the underlying mechanisms, an in silico molecular docking analysis was performed. This study examined the binding interactions of the extract’s phytoconstituents, identified through GC-MS, with two target proteins. A total of 16 compounds were evaluated for their potential binding to these proteins. One of the targets, TNF-α, was studied using the crystal structure PDB ID: 2AZ5, which is co-crystallized with a small molecule inhibitor. The co-crystallized ligand was found to occupy a relatively shallow pocket, forming interactions with amino acid residues across both subunits of the TNF-α dimer. In total, 16 residues participated in the ligand binding - seven from chain A and nine from chain B - with six tyrosine residues playing a role in the interaction. To confirm the reliability of the docking protocol, the original co-crystallized ligand was re-introduced into the binding site, and the results were comparable. Among the tested compounds, α-tocospiro B, stigmasterin, and α-amyrin exhibited notable binding affinities toward TNF-α, with binding energies ranging from –7.15 to –6.45 kcal/mol (Table 5). For comparison, the co-crystallized ligand had a binding energy of –8.23 kcal/mol. These compounds displayed interactions via hydrogen bonding with Tyr59 and Leu57 (Fig. 8).
Table 5. The docking scores obtained by the compounds identified in leaves of A. socotranum against the two target enzymes, TNF-α and TGF-βR1.
| Compound | Docking scores (kcal/mol) | |
|---|---|---|
| TNF-α(PDB ID: 2AZ5) | TGF-βR1(PDB ID: 6B8Y) | |
| Co-crystallized ligand 1 | –8.23 | –8.66 |
| Co-crystallized ligand 2 | –7.21 | |
| Methyl tetradecanoate | –6.50 | –7.24 |
| Methyl palmitate | –6.39 | –7.99 |
| Methyl 14-methylhexadecanoate | –6.29 | –8.18 |
| Methyl 10-octadecenoate | –6.66 | –8.44 |
| Methyl stearate | –6.84 | –7.86 |
| Arachidic acid methyl ester | –6.88 | –8.05 |
| 1,2-benzenedicarboxylic acid | –4.83 | –5.80 |
| Behenic acid methyl ester | –6.85 | –8.85 |
| Methyl lignocerate | –7.42 | –9.12 |
| α-tocospiro B | –7.15 | –9.65 |
| α-tocospiro A | –7.67 | –9.14 |
| Methyl hexacosanoate | –7.79 | –8.63 |
| Stigmasterin | –6.92 | –7.91 |
| β-sitosterol | –6.91 | –7.77 |
| Betulinaldehyde | –6.61 | –6.99 |
| α-amyrin | –6.45 | –5.19 |
| Co-crystallized ligand 1 | –8.23 | –8.66 |
| Co-crystallized ligand 2 | –7.21 | |
 | Figure 8. 2D binding interaction of α-amyrin (A), stigmasterin (B), and α-tocospiro B (C) showed notable binding affinities toward TNF-α [PDB ID: 2AZ5]. [Click here to view] |
The second protein target selected for docking analysis was TGF-βR1, based on its crystal structure available under PDB ID: 6B8Y. This structure includes a co-crystallized novel heterobicyclic pyrrolopyrimidine-based inhibitor, which demonstrated strong binding, with an affinity of –8.66 kcal/mol (Table 5). The referenced ligand formed two hydrogen bonds with residues Lys232 and Ile211, along with hydrophobic interactions involving His283 and Asp351 (Fig. 9). Out of the 16 screened phytoconstituents1,2-benzenedicarboxylic acid, α-tocospiro B, α-tocospiro A, α-amyrin, and betulinaldehyde exhibited binding energies ranging from –5.19 to –9.65 kcal/mol (Table 5). Specifically, 1,2-benzenedicarboxylic acid formed a hydrogen bond with Lys232 and hydrophobic interactions with Tyr249 and Asp351 (Fig. 9). α-tocospiro B interacted with Lys213 and Asp290, while α-tocospiro A formed a hydrogen bond with Lys213 and a hydrophobic interaction at residue 257 (Fig. 9). Similarly, α-amyrin exhibited hydrogen bonding with Lys213 and a hydrophobic interaction with Asp290 (Fig. 9).
 | Figure 9. The 2D binding modes of α-tocospiro A (A), α-tocospiro B (B), α-amyrin (C), 1,2-benzenedicarboxylic acid (D), betulinaldehyde (E), and co-crystal structure (heterobicyclic pyrrolopyrimidine derivative) (F) showed notable binding affinities toward TGF-βR1 [PDB ID: 6B8Y]. [Click here to view] |
DISCUSSION
The therapeutic properties of ASL may be attributed to its rich phytochemical composition. In this study, the phytochemical investigation of the ASL extract showed that the plant contains phenols, flavonoids, tannins, carbohydrates, phytosterols, triterpenes, diterpenes, saponins, and cardiac glycosides. These components were also reported in the leaf extract of Adenium obseum, another common Adenium species [28]. Many of these compounds are known to exert antioxidant, antimicrobial, antiviral, immunomodulation, and antineoplastic properties [29–31]. The therapeutic potential of these active constituents warrants further investigation to assess their potential in managing various diseases [32,33]. Herbal medicines are typically formulated from crude plant extracts containing a complex mix of phytochemicals with synergistic actions [33]. Isolating and identifying numerous bioactive molecules from medicinal plants has contributed to the development of potent pharmaceutical agents [34]. GC–MS is recognized as a highly efficient, rapid, and precise method for identifying a wide range of compounds, such as alcohols, alkaloids, steroids, esters, nitrogenous compounds, long-chain hydrocarbons, organic acids, and amino acids [35]. This technique also requires only a minimal quantity of plant extract for analysis. Consequently, the present study utilized GC–MS technique for the detection and identification of phytochemical compounds present in the ASL extract.
The GC-MS investigation of the ASL extract identified 16 distinct compounds, which may contribute to the biological properties of ASL. Among the identified compounds, methyl palmitate, methyl stearate, α-tocospiro A, β-sitosterol, and α-amyrin were the most abundant and are known to possess various biological properties. These activities include anti-inflammatory, antioxidant, antineoplastic, anti-fibrotic, and anthelmintic activities, along with liver, heart, and lung protective properties [36–40]. Methyl stearate has been shown to exert anthelmintic effects [40]. β-sitosterol is known for its antineoplastic, free radical scavenging, anti-inflammatory, immunoregulatory, and antidiabetic effects among other medicinal properties [41–43]. α-amyrin has demonstrated anti-inflammatory, free radical quenching, gastro-protective, antineoplastic, antidiabetic, and lipid-lowering effects [44–48]. The presence of these multifunctional compounds supports the potential of ASL extract as a therapeutic agent.
One of the primary mechanisms through which these phytochemicals exert their therapeutic effects is via antioxidant activity. In the present study, the ASL extract exhibited strong antioxidant potential as demonstrated by the DPPH free radical scavenging assay. This finding aligns with previous reports demonstrating that the Adenium species like A. obseum possess strong DPPH free-radical, superoxide-radical, ABTS-radical, and hydroxyl radical scavenging activities [28]. The antioxidant effect of the ASL extract may be due to the high phenolic content, as observed in the present study. Polyphenols, known for their potent antioxidant properties, likely can prevent oxidative stress-related damage associated with chronic diseases [49]. Additionally, the major compounds identified in the ASL, such as methyl palmitate, methyl stearate, α-tocospiro A, β-sitosterol, and α-amyrin, likely contribute to the extract’s free radical scavenging, either individually or synergistically. This antioxidant activity may work in concert with other properties to facilitate wound healing.
Building on its antioxidant properties, the ASL extract was further evaluated for its ability to promote tissue regeneration. Wound healing is a complex process involving three main phases: the inflammatory phase (hemostasis and inflammation), the proliferative phase (granulation, contraction, and epithelialization), and the remodeling phase, which strengthens newly formed tissues [50]. Any disruption in this process can result in delayed healing and chronic wounds [50]. Our findings confirm that the topical application of ASL extract twice daily significantly accelerates dermal wound healing in rats. Wounds treated with a higher concentration (20 mg/ml) of the ASL extract showed significantly greater reduction compared to untreated, vehicle-treated, and Solcoseryl jelly-treated wounds. Notable healing was observed from day 3 to 12. The extract’s healing efficacy was further confirmed through the analysis of hydroxyproline content and histopathological examination of the healed tissues.
Elevated hydroxyproline levels indicate enhanced collagen deposition, a key element in wound repair [8]. In the present investigation, a greater hydroxyproline content in the ASL extract groups was observed, indicating enhanced collagen formation and supporting the wound healing activity of ASL [8]. Notably, the ASL extract outperformed the standard treatment (Solcoseryl), highlighting its superior regenerative potential.
Histological analysis provided further evidence of enhanced tissue repair in ASL-treated wounds. In the current study, histopathological analysis revealed complete re-epithelialization, hair formation, and sebaceous gland development. Additionally, dense collagen fibers and active vascularization were observed in the granulation tissue of those ASL extract-treated wounds. During the initial stages of healing, the tissue typically exhibits increased vascularization through the formation of new blood vessels, with leukocyte recruitment to the wound site [51]. Wounds treated with the ASL extract exhibited an enhanced proliferative phase and fewer inflammatory cells compared to the vehicle-treated wounds. Fibroblast proliferation and collagen fiber production were significantly higher in the extract-treated wounds compared to both the vehicle and untreated groups, indicating accelerated progression through the inflammatory phase and transition into the maturation phase. The ASL extract’s anti-inflammatory properties likely accelerated wound regeneration by lessening the intensity of the inflammation at the wound area [52]. Active cellular division, along with collagen fiber formation, myofibroblast formation, and vascularization at the wound site, are critical processes involved in wound healing [53]. These histological improvements support the extract’s role in accelerating the healing process by modulating inflammation and promoting tissue regeneration.
To gain a deeper understanding of the wound-healing potential of phytochemicals present in the ASL extract, molecular docking simulations were carried out. Sixteen bioactive constituents were virtually screened against two critical proteins involved in tissue repair after injury: TNF-α and TGF-βR1. TNF-α, retrieved from PDB ID code:2AZ5, was previously crystallized with a known inhibitory small molecule [54]. Meanwhile, TGF-βR1, associated with regulating cellular growth and proliferation during wound healing [27], was represented by protein PDB ID code:6B8Y and co-crystallized with a novel heterobicyclic pyrrolopyrimidine derivative [55]. Docking outcomes revealed that several compounds, most notably α-tocospiro B, α-amyrin, and 1,2-benzenedicarboxylic acid, demonstrated strong affinity/binding for the active sites of these proteins. These compounds engaged in key interactions such as hydrogen bonding and hydrophobic associations, with amino acid residues critical to protein function, suggesting a plausible molecular basis for their contribution to the extract’s wound-healing effects. These molecular interactions provide mechanistic support for the wound-healing efficacy observed in vivo.
In addition to antioxidant effects, the antimicrobial activity of ASL may further enhance wound repair by reducing infection risk. Both microbial presence and oxidative stress are known to delay the wound healing process. Hence, agents possessing free radical scavenging and/or antibacterial properties may help enhance wound healing [56,57]. The present study confirmed that the ASL possessed significant antibacterial and antioxidant activities, which likely contribute to its wound-healing activity. The ASL extract showed potent antibacterial activity against all tested bacteria (E. faecalis, S. aureus, K. pneumoniae, and P. aeruginosa) using both disc-diffusion as well as broth microdilution assays These bacterial species were selected due to their clinical relevance, as they commonly cause and exacerbate skin infections, thereby complicating wound healing [58,59]. The bactericidal effect of the extract was comparable to that of gentamicin, a standard aminoglycoside antibiotic. These findings align with previous studies on the bactericidal efficacy of A. obesum, another Adenium species, against multiple bacteria [60,61]. Antimicrobials facilitate quicker and more effective wound healing by lowering or eliminating microbial contamination. Injured skin is particularly susceptible to various types of invasive microbial infections, which can cause inflammation and fluid discharge, thereby impeding healing [62]. The extract’s strong antibacterial activity likely contributes to its wound-healing potential, complementing its antioxidant and regenerative effects.
The efficacy of the ASL extract to promote wound healing likely arises from the synergistic interaction of multiple phytoconstituents. Previous studies have indicated that flavonoids, saponins, tannins, and phenolic bioactive compounds contribute to positive skin regenerative effects post-injury due to their bactericidal and astringent effects [63,64]. Additional research has shown that tannins enhance wound tissue regeneration by exhibiting antioxidant activity, facilitating wound contraction, and stimulating new blood vessel formation [65,66]. β-sitosterol, present in the ASL extract as shown in the current study, has demonstrated significant regenerative effects on diabetic wounds. These effects are attributed to promoting angiogenesis, stimulating macrophage activation, promoting proliferation, and enhancing collagen synthesis [67]. These collective findings underscore the relevance of multi-compound herbal extracts in skin regeneration therapies.
CONCLUSION
Taken together, the present findings underscore the multifaceted therapeutic potential of the ASL extract, driven by its diverse phytochemical profile. Notably, compounds such as methyl palmitate, methyl stearate, α-tocospiro A, β-sitosterol, and α-amyrin—identified through phytochemical and in silico analyses—are likely contributors to the observed antioxidant, antibacterial, and wound-healing activities. The combination of these properties highlights the promise of ASL as a natural agent for wound management. Future work should focus on isolating and characterizing these key bioactive compounds to validate their specific roles and further explore their potential impact in clinical wound care applications.
ACKNOWLEDGMENTS
The authors acknowledge the Faculty of Pharmacy and Faculty of Veterinary Medicine, Sana’a University, Yemen, for providing logistics support for conducting the experiments. Special thanks are extended to the Regional Center for Mycology and Biotechnology (RCMB) at Al-Azhar University, Cairo, Egypt, as well as Shiba Pharma and Global Pharma Companies (Sana’a, Yemen) and Sehatak and Yemen Lab for Medical Analyses (Sana’a, Yemen) for providing laboratory facilities.
AUTHORS’ CONTRIBUTION
All authors made substantial contributions to conception and design, acquisition of data, or analysis and interpretation of data; took part in drafting the article or revising it critically for important intellectual content; agreed to submit to the current journal; gave final approval of the version to be published; and agree to be accountable for all aspects of the work. All the authors are eligible to be an author as per the International Committee of Medical Journal Editors (ICMJE) requirements/guidelines
FINANCIAL SUPPORT
The authors received no financial support for the research, authorship, and/or publication of this article.
CONFLICTS OF INTEREST
The authors report no financial or any other conflicts of interest in this work.
ETHICAL APPROVAL
Animal-related investigations performed in this investigation were approved by the Institutional Ethical Committee, Faculty of Medicine and Health Sciences, Sana’a University, Sana’a, Yemen (Approval No. 02/FPhSana’a/2023).
DATA AVAILABILITY
All data generated and analyzed are included in this research article.
PUBLISHER’S NOTE
All claims expressed in this article are solely those of the authors and do not necessarily represent those of the publisher, the editors and the reviewers. This journal remains neutral with regard to jurisdictional claims in published institutional affiliation.
USE OF ARTIFICIAL INTELLIGENCE (AI)-ASSISTED TECHNOLOGY
The authors declares that they have not used artificial intelligence (AI)-tools for writing and editing of the manuscript, and no images were manipulated using AI.
REFERENCES
1. Miller AG, Morris M. Ethnoflora of the soqotra archipelago. Edinburgh, UK: Royal Botanic Garden Edinburgh; 2004.
2. Bawazir AA, Bamousa AS. Biodiversity and conservation of plant genetic resources on Socotra. Discourse J Agric Food Sci. 2014;2(7):217−24.
3. Sivamani RK, Ma BR, Wehrli LN, Maverakis E. Phytochemicals and naturally derived substances for wound healing. Adv Wound Care 2012;1(5):213−7. CrossRef
4. Ibrahim NI, Wong SK, Mohamed IN, Mohamed N, Chin K-Y, Ima-Nirwana S, et al. Wound healing properties of selected natural products. Int J Environ Res Public Health. 2018;15(11):2360. CrossRef
5. Agyare C, Akindele AJ, Steenkamp V. Natural products and/or isolated compounds on wound healing. Evid Based Complement Alternat Med. 2019;2019:4594965. CrossRef
6. Sharma A, Khanna S, Kaur G, Singh I. Medicinal plants and their components for wound healing applications. Futur J Pharm Sci. 2021;7(1):1−13. CrossRef
7. Ahmad I, Mehmood Z, Mohammad F. Screening of some Indian medicinal plants for their antimicrobial properties. J Ethnopharmacol. 1998;62(2):183−93. CrossRef
8. Agarwal P, Singh A, Gaurav K, Goel S, Khanna H, Goel R. Evaluation of wound healing activity of extracts of plantain banana (Musa sapientum var. paradisiaca) in rats. Indian J Exp Biol. 2009;47:32−40.
9. Liguori I, Russo G, Curcio F, Bulli G, Aran L, Della-Morte D, et al. Oxidative stress, aging, and diseases. Clin Interv Aging. 2018;13:757−72. CrossRef
10. Omar HH, Al-Judaibiand A, El-Gendy A. Antimicrobial, antioxidant, anticancer activity and phytochemical analysis of the red alga, Laurencia papillosa. Int J Pharmacol. 2018;14(4):572−83.
11. Gulumian M, Yahaya ES, Steenkamp V. African herbal remedies with antioxidant activity: a potential resource base for wound treatment. Evid Based Complement Altern Med. 2018;2018:4089541. CrossRef
12. Shaikh JR, Patil M. Qualitative tests for preliminary phytochemical screening: an overview. Int J Chem Stud. 2020;8(2):603−8. CrossRef
13. Visweswari G, Christopher R, Rajendra W. Phytochemical screening of active secondary metabolites present in Withania somnifera root: role in traditional medicine. Int J Pharm Sci Res. 2013;4(7):2770. CrossRef
14. Elgerwi AA, Benzekri Z, El-Magdoub A, El-Mahmoudy A. Qualitative identification of the active principles in Citrullus colocynthis and evaluation of its teratogenic effects in albino rats. Int J Basic Clin Pharmacol. 2013;2(4):438−45. CrossRef
15. Waterhouse AL. Determination of total phenolics. Curr Protocols Food Anal Chem. 2002;6(1):I1. 1.1−8.
16. Moharram BA, AL-Mahbashi HM, Al-Maqtari T, Saif-Ali R, Al-Hakami IA, Alhaj WT. Leaves of Capparis cartilaginea exhibit a promising antidiabetic activity in alloxan-induced diabetic rats. J Pharm Res Allied Sci. 2023;12(4):65−75.
17. Moharram BA, Al-Mahbashi HM, Saif-Ali R, AliAqlan F. Phytochemical, anti-inflammatory, antioxidant, cytotoxic and antibacterial study of Capparis cartilaginea decne from Yemen. Int J Pharm Pharm Sci. 2018;10(6):38−44. CrossRef
18. Elshikh M, Ahmed S, Funston S, Dunlop P, McGaw M, Marchant R, et al. Resazurin-based 96-well plate microdilution method for the determination of minimum inhibitory concentration of biosurfactants. Biotechnol Lett. 2016;38:1015−9. CrossRef
19. Wayne P. Performance standards for antimicrobial susceptibility testing: twenty-second informational supplement. Wayne, PA: Clinical and Laboratory Standards Institute M100-S22 USA; 2012.
20. Moharram BA, Al-Mahbashi HM, Al-Maqtari T, Saif-Ali R, A-Doaiss AA. Aloe irafensis an endemic plant of Yemen: phytochemical screening, antibacterial, antioxidant, and wound healing activities. Asian J Pharm Clin Res. 2021;14(10):88−94. CrossRef
21. Alsarayreh AZa, Attalah Oran S, Shakhanbeh JM. In vitro and in vivo wound healing activities of Globularia arabica leaf methanolic extract in diabetic rats. J Cosmet Dermatol. 2022;21(10):4888−900. CrossRef
22. Tsala DE, Amadou D, Habtemariam S. Natural wound healing and bioactive natural products. Phytopharmacology 2013;4(3):532−60.
23. Thangaraj P. Pharmacological assays of plant-based natural products. Geneva, Switzerland: Springer; 2016.
24. Azis H, Taher M, Ahmed A, Sulaiman W, Susanti D, Chowdhury S, et al. In vitro and In vivo wound healing studies of methanolic fraction of Centella asiatica extract. S Afr J Bot. 2017;108:163−74. CrossRef
25. Bancroft JD, Layton C, Suvarna SK. Bancroft’s theory and practice of histological techniques. Amsterdam, Netherland: Churchill Livingstone Elsevier; 2013.
26. Xue F, Huang J, Ji H, Fang J, Li H, Martásek P, et al. Structure-based design, synthesis, and biological evaluation of lipophilic-tailed monocationic inhibitors of neuronal nitric oxide synthase. Bioorg Med Chem. 2010;18(17):6526−37. CrossRef
27. Shady NH, Mostafa NM, Fayez S, Abdel-Rahman IM, Maher SA, Zayed A, et al. Mechanistic wound healing and antioxidant potential of Moringa oleifera seeds extract supported by metabolic profiling, in silico network design, molecular docking, and in vivo studies. Antioxidants 2022;11(9):1743. CrossRef
28. Alshehri A, Ahmad A, Tiwari RK, Ahmad I, Alkhathami AG, Alshahrani MY, et al. In vitro evaluation of antioxidant, anticancer, and anti-inflammatory activities of ethanolic leaf extract of Adenium obesum. Front Pharmacol. 2022;13:847534. CrossRef
29. Akhtar MS, Hossain MA, Said SA. Isolation and characterization of antimicrobial compound from the stem-bark of the traditionally used medicinal plant Adenium obesum. J Tradit Complement Med. 2017;7(3):296−300. CrossRef
30. Hossain MA, Akhtar MS, Said S, Al-Abri THA. Two new flavonoids from Adenium obesum grown in Oman. J King Saud Univ Sci. 2017;29(1):62−9. CrossRef
31. Hossain MA. A review on Adenium obesum: a potential endemic medicinal plant in Oman. Beni Suef Univ J Basic Appl Sci. 2018;7(4):559−63. CrossRef
32. Anand U, Jacobo-Herrera N, Altemimi A, Lakhssassi N. A comprehensive review on medicinal plants as antimicrobial therapeutics: potential avenues of biocompatible drug discovery. Metabolites 2019;9(11):258. CrossRef
33. Pandey MM, Rastogi S, Rawat A. Indian herbal drug for general healthcare: an overview. Internet J Altern Med. 2008;6(1):3.
34. Yadav R, Khare R, Singhal A. Qualitative phytochemical screening of some selected medicinal plants of shivpuri district (mp). Int J Life Sci Scienti Res. 2017;3(1):844−7. CrossRef
35. Razack S, Hemanth Kumar K, Nallamuthu I, Naika M, Khanum F. Antioxidant, biomolecule oxidation protective activities of Nardostachys jatamansi DC and its phytochemical analysis by RP-HPLC and GC-MS. Antioxidants 2015;4(1):185−203. CrossRef
36. Jaleel GAA, Azab SS, El-Bakly WM, Hassan A. Methyl palmitate attenuates adjuvant induced arthritis in rats by decrease of CD68 synovial macrophages. Biomed Pharmacother. 2021;137:111347. CrossRef
37. Breeta RDIE, Grace VMB, Wilson DD. Methyl palmitate—a suitable adjuvant for Sorafenib therapy to reduce in vivo toxicity and to enhance anti-cancer effects on hepatocellular carcinoma cells. Basic Clin Pharmacol Toxicol. 2021;128(3):366−78. CrossRef
38. Saeed NM, El-Demerdash E, Abdel-Rahman HM, Algandaby MM, Al-Abbasi FA, Abdel-Naim AB. Anti-inflammatory activity of methyl palmitate and ethyl palmitate in different experimental rat models. Toxicol Appl Pharmacol. 2012;264(1):84−93. CrossRef
39. Arab HH, Salama SA, Eid AH, Kabel AM, Shahin NN. Targeting MAPKs, NF-κB, and PI3K/AKT pathways by methyl palmitate ameliorates ethanol-induced gastric mucosal injury in rats. J Cell Physiol. 2019;234(12):22424−38. CrossRef
40. Lu Q, Liu T, Wang N, Dou Z, Wang K, Zuo Y. Nematicidal effect of methyl palmitate and methyl stearate against meloidogyne incognita in bananas. J Agric Food Chem. 2020;68(24):6502−10. CrossRef
41. Saeidnia S, Manayi A, Gohari AR, Abdollahi M. The story of beta-sitosterol-a review. European J Med Plants. 2014;4(5):590−609. CrossRef
42. Wen Y, Pang L, Fan L, Zhou Y, Li R, Zhao T, et al. β-Sitosterol inhibits the proliferation of endometrial cells via regulating Smad7-mediated TGF-β/smads signaling pathway. Cell J (Yakhteh). 2023;25(8):554. CrossRef
43. da Silva Marineli R, Furlan CPB, Marques AyC, Bicas J, Pastore GM, Maróstica MR Jr. Phytosterols: biological effects and mechanisms of hypocholesterolemic action. In: Vijai Kumar G, Maria GT, Mohtashim L, Anthonia OD, editors. Biotechnology of bioactive compounds: sources and applications. 1st ed. West Sussex, UK: John Wiley & Sons, Ltd.; 2015. pp 565−81.
44. Santos FA, Frota JT, Arruda BR, de Melo TS, da Silva AAdCA, Brito GAdC, et al. Antihyperglycemic and hypolipidemic effects of α, β-amyrin, a triterpenoid mixture from Protium heptaphyllum in mice. Lipids Health Dis. 2012;11:1−8. CrossRef
45. Barros FW, Bandeira PN, Lima DJ, Meira AS, de Farias SS, Albuquerque MRJ, et al. Amyrin esters induce cell death by apoptosis in HL-60 leukemia cells. Bioorg Med Chem. 2011;19(3):1268−76. CrossRef
46. Biskup E, Golebiowski M, Gniadecki R, Stepnowski P, Lojkowska E. Triterpenoid α-amyrin stimulates proliferation of human keratinocytes but does not protect them against UVB damage. Acta Biochim Pol. 2012;59(2):255−60. CrossRef
47. Oliveira FA, Vieira-Júnior GM, Chaves MH, Almeida FR, Santos KA, Martins FS, et al. Gastroprotective effect of the mixture of α-and β-amyrin from Protium heptaphyllum: role of capsaicin-sensitive primary afferent neurons. Planta Med. 2004;70(08):780−2. CrossRef
48. Viet TD, Xuan TD, Anh LH. α-amyrin and β-amyrin isolated from Celastrus hindsii leaves and their antioxidant, anti-xanthine oxidase, and anti-tyrosinase potentials. Molecules 2021;26(23):7248. CrossRef
49. Del Rio D, Rodriguez-Mateos A, Spencer JP, Tognolini M, Borges G, Crozier A. Dietary (poly) phenolics in human health: structures, bioavailability, and evidence of protective effects against chronic diseases. Antioxid Redox Signal. 2013;18(14):1818−92. CrossRef
50. Singh S, Singh R, Kumar N, Kumar R. Wound healing activity of ethanolic extract of Plantago ovata (Ispaghula) seeds. J Appl Pharm Sci. 2011;1(7):108−11.
51. Deonarine K, Panelli MC, Stashower ME, Jin P, Smith K, Slade HB, et al. Gene expression profiling of cutaneous wound healing. J Transl Med. 2007;5:1−11. CrossRef
52. Rezaie A, Najafzadeh H, Poormahdi-Broojeni M, Mohammadian B, Heidari M. Effects of Echinacea Purpurea on wound healing after arsenic induced skin necrosis. Zahedan J Res Med Sci. 2013;15(11):19.
53. Sarkar M, Das G, Pathak SK, Maitra S, Samanta A. Evaluation of in vivo wound healing and in vitro antibacterial activities of the different extract of Leucas indica Linn. Int J Pharm Pharm Sci. 2013;5(3):333−40.
54. He MM, Smith AS, Oslob JD, Flanagan WM, Braisted AC, Whitty A, et al. Small-molecule inhibition of TNF-α. Science 2005;310(5750):1022−5. CrossRef
55. Harikrishnan LS, Warrier J, Tebben AJ, Tonukunuru G, Madduri SR, Baligar V, et al. Heterobicyclic inhibitors of transforming growth factor beta receptor I (TGFβRI). Bioorg Med Chem. 2018;26(5):1026−34. CrossRef
56. Lopes GC, Sanches AC, Nakamura CV, Dias Filho BP, Hernandes L, de Mello JCP. Influence of extracts of Stryphnodendron polyphyllum Mart. and Stryphnodendron obovatum Benth. on the cicatrisation of cutaneous wounds in rats. J Ethnopharmacol. 2005;99(2):265−72. CrossRef
57. Sasidharan S, Nilawatyi R, Xavier R, Latha LY, Amala R. Wound healing potential of Elaeis guineensis JacqLeaves in an infected albino rat model. Molecules 2010;15(5):3186−99. CrossRef
58. Dworniczek E, Piwowarczyk J, Bania J, Kowalska-Krochmal B, Walecka E, Seniuk A, et al. Enterococcus in wound infections: virulence and antimicrobial resistance. Acta Microbiol Immunol Hung. 2012;59(2):263−9. CrossRef
59. Saaiq M, Ahmad S, Zaib MS. Burn wound infections and antibiotic susceptibility patterns at Pakistan Institute of Medical Sciences, Islamabad, Pakistan. World J Plast Surg. 2015;4(1):9.
60. Tijjani A, Ndukwe I, Ayo R. Studies on antibacterial activity of Adenium obesum (Apocynaceae) stembark. Cont J Microbiol 2011;5(1):12−7.
61. Al Rashdi RSY, Hossain MA, Al Touby SSJ. Antioxidant and antibacterial activities of leaves crude extracts of Adenium obesum grown in Oman National Botanical Garden. Adv Biomark Sci Technol. 2021;3:8−14. CrossRef
62. Woods C. Subcutaneous tissue infections and abscesses. In: Long SS, editor. Principles and practice of pediatric infectious siseases. 6th ed. Philadelphia, PA: Elsevier; 2023. pp 478−85.e2.
63. Ilodigwe E, Ndunagu L, Ajaghaku D, Utoh-Nedosa U. Evaluation of the wound healing activity of a polyherbal remedy. Ann Biol Res. 2012;3(11):5393−8.
64. Kommu S, Gowrishankar N, Kamala D, Saritha B, Srinivasulu V, Naresh B, et al. Evaluation of wound healing activity of methanolic extract of Balanites aegyptiaca L. leaves. Int J Pharm Pharm Sci. 2013;5(2):52−3.
65. Deters A, Dauer A, Schnetz E, Fartasch M, Hensel A. High molecular compounds (polysaccharides and proanthocyanidins) from Hamamelis virginiana bark: influence on human skin keratinocyte proliferation and differentiation and influence on irritated skin. Phytochemistry 2001;58(6):949−58. CrossRef
66. Fernandez O, Capdevila J, Dalla G, Melchor G. Efficacy of Rhizophora mangle aqueous bark extract in the healing of open surgical wounds. Fitoterapia 2002;73(7−8):564−8. CrossRef
67. Liu Y, Li Z, Li W, Chen X, Yang L, Lu S, et al. Discovery of β-sitosterol’s effects on molecular changes in rat diabetic wounds and its impact on angiogenesis and macrophages. Int Immunopharmacol. 2024;126:111283. CrossRef